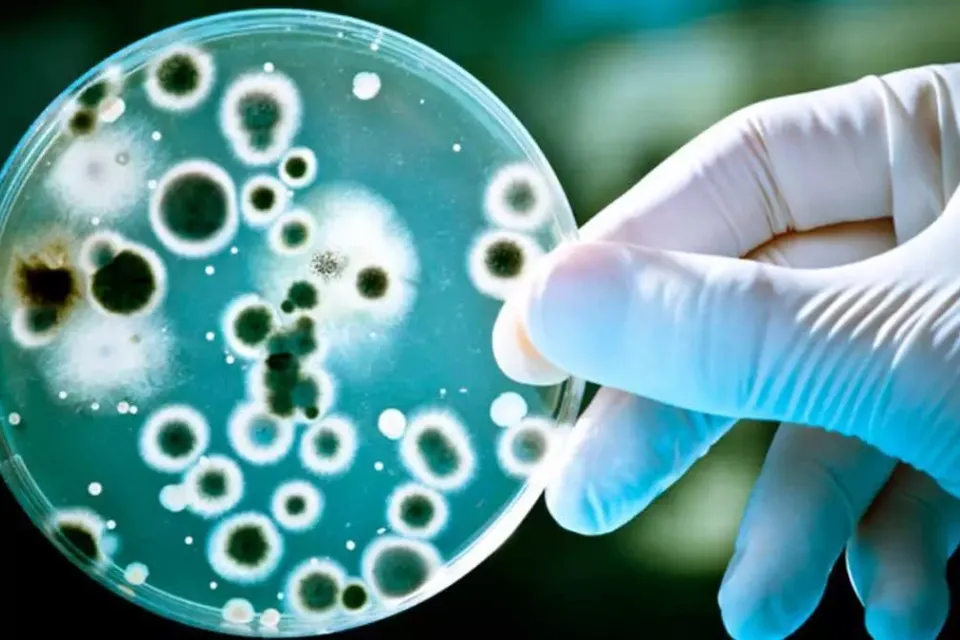
Bacterias

La resistencia a los antibióticos puede matar a más de 200 millones de personas en 25 años
Los antibióticos fueron el gran descubrimiento médico de la primera parte del siglo XX. El problema es que las bacterias y patógenos tienen la capacidad de mutar y burlar la capacidad de los fármacos hasta el punto de que la llamada resistencia a los antibióticos se ha convertido en una de las 10 principales amenazas a la salud mundial, según la OMS.
En este escenario, la reconocida revista ‘The Lancet’ ha publicado una investigación que pronostica que de 2025 a 2050, en tan solo 25 años, se producirán 39 millones de muertes de forma directa y 169 de manera indirecta por la resistencia a los antibióticos, lo que supone un total de 208 millones de decesos.
La principal novedad de la macro investigación es que incluye las primeras estimaciones a nivel mundial de la mortalidad por resistencias a los antibióticos en las últimas tres décadas, de 1990 a 2021, para 22 patógenos y 16 antimicrobianos, en 204 países y territorios. Este compendio de datos supera los estudios realizados sobre un número más limitado de bacterias o más regionalizados.
Asimismo, el trabajo incluye las proyecciones futuras, lo que pone de relieve que la resistencia a los antibióticos “ha sido una significativa amenaza para la sanidad global durante décadas y que la amenaza está aumentando”, según avisa el autor principal de estudio, Mohsen Naghavi, líder del equipo de investigación de RAM en Instituto de Métricas de Salud (IHME) de la Universidad de Washington (EEUU).
El aumento
En concreto, la investigación indica que entre 1990 y 2021 cada año fallecieron más de un millón de personas y que las muertes aumentarán un 70% en 2050, sobre todo en personas mayores y en sur y este de Asia, Oceanía y África Subsahariana. Además, existe una tendencia dispar. Así, mientras que en niños menores de cinco años los decesos han caído 50% en las últimas tres décadas, las muertes entre personas de más de 70 años se han incrementado 80%.
Por todo ello, según el principal autor del estudio, analizar pormenorizadamente la evolución de la mortalidad provocada por este grave problema y cómo cambiará en el futuro es “vital para tomar decisiones y salvar vidas”.
Coincide con esta interpretación el doctor español Rafael Cantón, portavoz de la Sociedad Española de Enfermedades Infecciosas y Microbiología Clínica (SEIMC), quien interpreta que la macro investigación demuestra que los pronósticos sobre la mortalidad provocada por la resistencia a los antibióticos realizados con anterioridad eran “ciertos, que el problema va empeorando y que si seguimos así, causará un número elevado de muertes”, por lo que “hay que ponerse a trabajar con más energía y decisión”.
De hecho, el trabajo publicado en ‘The Lancet’ revela que entre 2025 y 2050 podrían evitarse 92 millones de muertes, de las que 11,1 millones corresponden a las vidas salvadas por el desarrollo de nuevos antimicrobianos, si se toman las medidas adecuadas.
Las medidas
La OMS y la UE tienen planes destinados a mitigar la amenaza, pero hay que incrementar las acciones destinadas a prevenir las infecciones, a aumentar las tasas de vacunación, el acceso al sistema sanitario y reducir el uso inadecuado de antibióticos entre animales y humanos, que es una de las causas de que se hayan incrementado las resistencias, además de que las bacterias tienen a acumular las mutaciones resistentes a los fármacos.
En España se están implementado medidas pero “aún insuficientes” para cumplir con las tasas de reducción marcadas por la UE para 2030, por lo que el doctor Cantón propone incidir en las medidas de control de las infecciones, sobre todo en hospitales; en la implementación de diagnósticos rápidos y en la disminución del uso de antibióticos, concienciando a médicos y pacientes de que solo se usen cuando sean necesarios.
Con información de Público


Medicamentos para adelgazar: el reto de mantener el peso tras el tratamiento


Taylor Swift enfrenta demanda por el título de su último álbum “The Life of a Showgirl”



Alarma en la NASA: nueve científicos vinculados a proyectos sensibles han muerto


El renacer de Portugal: destinos imprescindibles para visitar esta primavera




